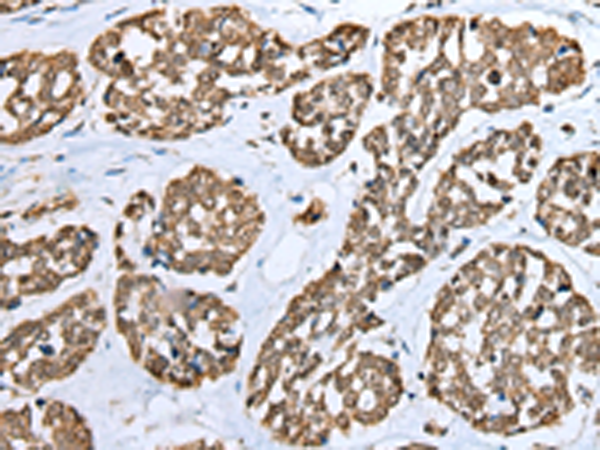
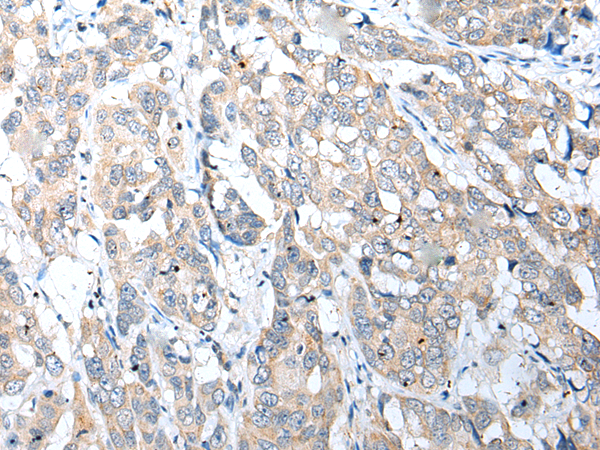

-
分类: 科研抗体货号: P02108别名:应用: WB,IHC反应种属: Human, Mouse
-
分类: 科研抗体货号: P02153别名: p24; p25; TPPP1; TPPP/p25; p25alpha应用: WB,IHC反应种属: Human, Mouse, Rat
-
分类: 科研抗体货号: P02152别名: ED3; EDA3; ECTD11A; ECTD11B应用: IHC反应种属: Human
-
分类: 科研抗体货号: P02116别名: MBP2; MBPH应用: IHC反应种属: Human
-
分类: 科研抗体货号: P02150别名: MARCH2; RNF172; HSPC240; MARCH-II应用: WB反应种属: Human, Mouse, Rat
-
分类: 科研抗体货号: P02115别名: BCL7应用: IHC反应种属: Human, Mouse
-
分类: 科研抗体货号: P02144别名:应用: WB,IHC反应种属: Human, Mouse
-
分类: 科研抗体货号: P02184别名: TSC; CHP3应用: IHC反应种属: Human, Mouse
-
分类: 科研抗体货号: P02143别名: DIPP2; HDCMB47P; DIPP2beta; DIPP2alpha应用: IHC反应种属: Human, Mouse, Rat
-
分类: 科研抗体货号: P02183别名: WSMN; MRX72应用: WB,IHC反应种属: Human, Mouse

鄂公网安备42018502007531号
鄂公网安备42018502007531号

